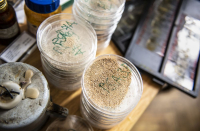
VS1_6567_original

Je to unikátní a dnes velmi progresivní obor. Zájem o něj stoupá i proto, že přináší odpovědi na otázky, které se vynořují s globální klimatickou krizí. Geobiologie je poměrně mladá, ale mimořádně perspektivní mezioborová vědní disciplína, kterou lze v České republice studovat na jediné instituci – Přírodovědecké fakultě UK.

Už dvě dekády mají zájemci možnost studovat moderní a progresivní bakalářský program Praktická geobiologie, respektive navazující magisterský program Geobiologie. Obory, jejichž unikátnost tkví v tom, že kombinují vědy o živé a neživé přírodě, a zvláště pak paleontologii, historickou geologii, geochemii nebo ekologii, vybudovala na PřF UK paleontoložka profesorka Katarína Holcová.

Katarína Holcová s replikou dinosauří kostry Cornotaura v univerzitním Chlupáčovu muzeu historie Země.
„Obor Praktická geobiologie jsme zakládali s tím, že bychom rádi vychovali obecněji vzdělaného přírodovědce, který by se orientoval jak v neživé, tak v živé přírodě. Přídomek ‚praktická‘ v názvu oboru měl svoje opodstatnění. Studenti v rámci volitelných předmětů mají možnost specializovat se na uplatnění v menších regionálních institucích, na správách chráněných krajinných oblastí nebo v regionálních muzeích, kde by po absolvování už bakalářského studia měli být schopní pečovat o problematiku jak živé, tak neživé přírody. V tom je jejich hlavní výhoda,“ vysvětlila Katarína Holcová, ředitelka Ústavu geologie a paleontologie PřF UK a garantka oboru.

Tím, že se studující učí jak základy biologie, tak i geologie, vzniká tím už v rané fázi studia specialista, který se na klasicky koncipovaných oborech obvykle dostane k druhému oboru až v pozdějších stupních studia a většinou v nich nepronikne až do takové hloubky, jak by bylo třeba, podotýká profesorka Holcová. „Sama dnes, jako vystudovaná geoložka, cítím, že mi některé bazální biologické vědomosti chybí. Vždy jsem samu sebe v biologii vnímala jako poučeného laika. Jsem proto ráda, že tu díky našemu oboru vyrůstá generace, která bude mít seriózní základy jak v biologii, tak v geologii,“ podotkla.

Absolventům studia se otevírají dveře jak do soukromé, tak státní sféry, do různých ekologických organizací, do státních úřadů nebo do energetických či těžařských firem. Někteří se vydávají také za katedru, protože díky nabytým znalostem mohou po získání pedagogického minima učit biologii, zeměpis nebo přírodopis. Kdo chce pokračovat ve studiu, může zvolit navazující Geobiologii, což je už čistě vědecky orientovaný obor, případně pokračovat v samostatném programu biologickém nebo geologickém. Několik studentů studuje i program Ochrana životního prostředí.

„Většina studentů pokračuje v paleobiologickém směru. Věnují se různým etapám vývoje života a interakcím, tedy jak na vývoj života dopadají změny fyzikálních a chemických parametrů prostředí, což je velmi aktuální v souvislosti s globálními klimatickými změnami a znečištěním životního prostředí,“ upozornila vědkyně.

Když obor v Praze na Albertově stavěla, ve stejné době vznikal i na etablovaných univerzitách v Evropě i v USA. Dnes patří mezi průkopníky tohoto moderního oboru třeba Skandinávie. A s tím, jak se společnost snaží porozumět globálním klimatickým změnám, nabývá stále na větší aktuálnosti a také popularitě.
Sama Katarína Holcová vystudovala geologii. K přírodním vědám se přitom dostala víceméně náhodou, protože za minulého režimu nemohla kvůli svému kádrovému posudku studovat humanitní vědy, ke kterým ji to původně táhlo.

„Soudružka ředitelka si mě před podáním přihlášky na vysokou školu pozvala do ředitelny a naznačila mi, že pokud chci studovat, tak musím volit jenom z určitých oborů, třeba geologii, která má blízko k tehdy strategickému hornictví. Tak jsem to zkusila, protože jsem na vysokou školu opravdu chtěla. Studium mě nakonec nadchlo, a protože mě to víc táhlo k živé přírodě, stala jsem se paleontoložkou. Zaměřila jsem se na mikropaleontologii, která se využívá třeba i v ropném průmyslu,“ vzpomínala.

Profesorka Katarína Holcová se ve svém výzkumu dlouhodobě zabývá mikroorganismy a celými ekosystémy, jež obývaly pravěká moře. Jedno z nich relativně nedávno (před 25–14 miliony let) pokrývalo oblast dnešní střední Evropy včetně Moravy. Díky studiu nenápadných a zdánlivě nezajímavých drobných organismů, které žily na dně moře nebo plavaly na povrchu jako plankton, pomáhá její tým dotvářet mozaiku toho, jak tehdejší ekosystémy vypadaly, vznikaly i zanikaly a vzájemně se ovlivňovaly. Pochopení minulosti totiž pomáhá porozumět nejenom dávnému vývoji života na Zemi, ale také současnosti. A to je také cílem celého vědního oboru geobiologie, který se po jejím několikaletém úsilí mohl otevřít v Praze.
| prof. RNDr. Katarína Holcová, CSc. |
| Absolvovala Přírodovědeckou fakultu UK, kde dnes vede Ústav geologie a paleontologie. Zabývá se taxonomií, biostratigrafií a paleoekologií foraminifer a vápnitého nanoplanktonu (období paleozoikum, kenozoikum). Vedle paleontologie se věnuje také didaktice geologie. Je úspěšnou řešitelkou řady projektů, které podpořila např. Grantová agentura ČR. |